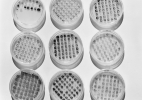
ALGAE01

Gallery Luisotti and Royale Projects are pleased to announce, Micrographia, the first joint exhibition of Karen Lofgren and Catherine Wagner, opening July 27th, 2022. In response to momentous developments in biological science in the late 20th century (e.g., the Human Genome Project or Dolly the sheep), Wagner photographs laboratories used for cellular, genetic, and genomic research, gleaning them for abstract compositions and larger cultural truths. Lofgren, on the other hand, looks to both ancient and emerging scientific fields, researching life’s elemental drives and abounding threats through embodiment and rituals. Inspired by the odd similarity between the biomorphic sculptures and the cross-sections of cells in the photographs, this show stages dialogue between healing practices and the biological industry, individual techniques of the body and the large-scale management of disease.
For some of these photographs, as if the camera itself were a measuring instrument, Wagner looked at beakers and petri dishes as objectively and impartially as possible, just how scientists handle their own objects of study. For others, Wagner took an active role in the scientific process, requiring collaboration with the scientists and the use of their equipment, such as Magnetic Resonance Imaging and Scanning Electron Microscopes. Despite these amicable exchanges, Wagner’s practice can also be seen to disrupt science. By refining aesthetically pleasing images from what are otherwise utilitarian objects, Wagner stalls the seemingly inexhaustible march towards new discovery. Scientific evidence, here, is not used to prove or disprove a narrow hypothesis, but rather as an access to point to the collective unconsciousness.
Lofgren presents two different types of sculptures: DEFENDERS (spiky, electrically colored resin objects) and a series of portals (sleek, steel figures) titled, PULLING THROUGH. Inspired by lethal tropical caterpillars, the DEFENDERS allude to the intensification of beauty amidst ecosystem collapse, a tragedy witnessed by the artist during research in the Amazon rainforest (2015-2018). The portals respond to ancient healing rituals, which entail movement through peculiar thresholds, such as the rungs of a bed or two graves underground. As viewers circulate around the gallery – perhaps noticing how the sculptures index their own limbs and orifices – they are invited to reflect on a series of transformations, including symbolic rebirth, the transference of a disease, the absorption of an object, or the creation of a barrier between a patient and his or her ailment.
Karen Lofgren (*1976 Toronto) is a graduate of CalArts and uses a diverse range of materials, such as bronze, wood, cloth or paper, to create sculptures and installations. Raised in a Dharma Center in the Mahyana Tibetan Buddhist tradition, Lofgran has always been attuned to matter’s animism. She works from a feminist, decolonial perspective and considers all living creatures to be sentient.
Catherine Wagner (* 1953 San Francisco) received a Master of Arts from SFSU and has been the head of photography at Mills College, now part of Northeastern Univ. since 1979 as the Nancy Cook Endowed Chair in Photography. Working in the tradition of the New Topographics, she first gained international acclaim for her show Moscone Center (1978), which shed light on the gentrification of San Francisco’s South of Market neighborhood. She is dedicated to the study of human systems, especially as access points to widespread knowledge and the collective unconscious.
Both artists have received Guggenheim Fellowships, Wagner has received a National Endowment for the Arts Fellowship and The Rome Prize, whereas, Lofgren has received a Fulbright and the Pollock-Krasner Award. Both have exhibited extensively throughout the U.S. and internationally, some highlights include the Whitney Museum of Art, Berkeley Art Museum, DAAD Galerie Berlin, National Academy of Science in D. C., Canadian Center for Architecture, Montreal, Mount Wilson Observatory, and Museum Folkwang, Essen.
For more information please email us at: info@galleryluisotti.com or info@royaleprojects.com